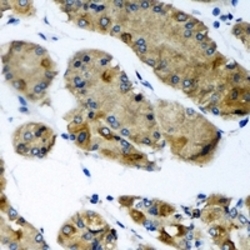

Antibody data
- Antibody Data
- Antigen structure
- References [0]
- Comments [0]
- Validations
- Western blot [1]
- Immunohistochemistry [1]
Submit
Validation data
Reference
Comment
Report error
- Product number
- LS-C482994 - Provider product page

- Provider
- LSBio
- Product name
- CEP57L1 Antibody LS-C482994
- Antibody type
- Polyclonal
- Description
- Immunoaffinity purified
- Reactivity
- Human
- Host
- Rabbit
- Storage
- Aliquot and store at -20°C for 1 year. Avoid freeze/thaw cycles.
No comments: Submit comment
Enhanced validation
- Submitted by
- LSBio (provider)
- Enhanced method
- Genetic validation
- Main image

- Experimental details
- Western blot analysis of CEP57L1 expression in BT474 (A); 22RV1 (B) whole cell lysates.
Supportive validation
- Submitted by
- LSBio (provider)
- Enhanced method
- Genetic validation
- Main image
- Experimental details
- Immunohistochemical analysis of CEP57L1 staining in human gastric cancer formalin fixed paraffin embedded tissue section. The section was pre-treated using heat mediated antigen retrieval with sodium citrate buffer (pH 6.0). The section was then incubated with the antibody at room temperature and detected using an HRP conjugated compact polymer system. DAB was used as the chromogen. The section was then counterstained with hematoxylin and mounted with DPX.